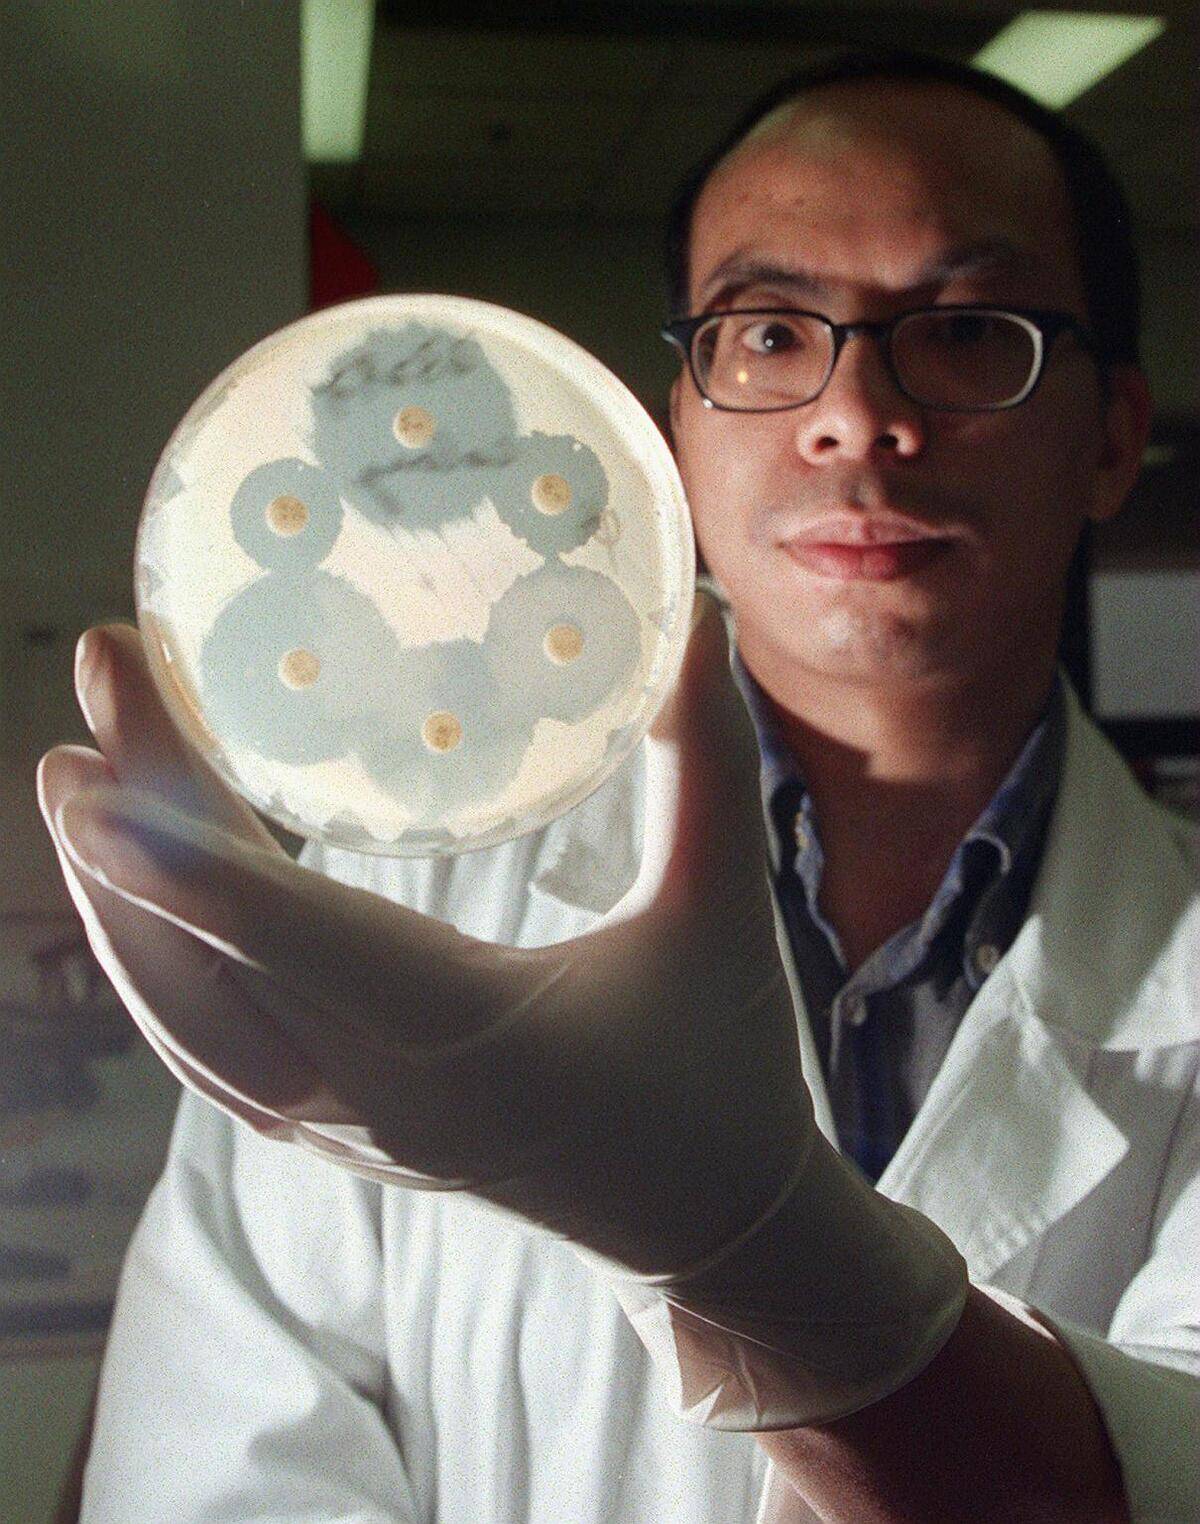

The history of Penicillin and how it was discovered by accident
In the realm of scientific discoveries, few have had as profound an impact on humanity as penicillin. This unassuming antibiotic, stumbled upon by accident, revolutionized the field of medicine.
It’s fascinating to think that a chance event in a cluttered laboratory would lead to the saving of countless lives. Penicillin’s story is a testament to the power of serendipity and the relentless pursuit of knowledge.
The Pre-Penicillin World: A Brief Overview of Medicine

Before penicillin, bacterial infections were often a death sentence. Simple cuts and scrapes could lead to life-threatening conditions like sepsis or gangrene. Doctors relied heavily on antiseptics, which were harsh and not always effective.
Surgery was a risky endeavor, with high infection rates. The medical world was in desperate need of a breakthrough, setting the stage for penicillin’s life-altering debut.
Alexander Fleming: The Man Behind the Discovery

Alexander Fleming, a Scottish bacteriologist, was the mind behind penicillin’s discovery. Known for his meticulous work, he was also noted for his curiosity about naturally occurring antibacterial agents.
Fleming’s keen observations and diligent note-taking were crucial in recognizing the significance of what many might have dismissed as a simple oversight. Without his sharp scientific intuition, penicillin might have remained undiscovered.
The Serendipitous Occurrence: How It All Began

The story of penicillin’s discovery begins with a messy lab and a forgotten petri dish. In 1928, after returning from a holiday, Fleming noticed something unusual.
A mold had contaminated one of his petri dishes, but curiously, the bacteria surrounding the mold had been destroyed. This seemingly mundane observation sparked one of the most significant medical breakthroughs of the 20th century.
The Role of the Dirty Petri Dish

The infamous dirty petri dish was not just an accident but a catalyst for discovery. Fleming had been studying staphylococci bacteria, and the mold that appeared was later identified as Penicillium notatum.
The area around the mold was clear, indicating its antibacterial properties. This chance occurrence demonstrated the importance of keeping an open mind and being observant, even in seemingly messy situations.
The Unlikely Hero: Penicillium Notatum Mold

Penicillium notatum, an ordinary mold, became an extraordinary hero. It produces a substance that inhibits bacterial growth, which Fleming aptly named penicillin.
This mold, often found in nature without much fanfare, turned out to be a game-changer in the fight against bacterial infections. It’s a reminder that sometimes the most powerful solutions come from the most unexpected places.
Fleming’s Eureka Moment: Realizing the Potential

Fleming’s eureka moment came when he realized the mold’s potential to combat harmful bacteria. He saw that penicillin could be harnessed to treat infections that were previously untreatable.
Despite the initial surprise, Fleming was quick to understand the implications.
Initial Skepticism: The Scientific Community’s Reaction

Despite Fleming’s enthusiasm, the scientific community was initially skeptical. Many dismissed the findings as insignificant or impractical for widespread use.
There was doubt about the ability to produce penicillin in quantities large enough for clinical use. Indeed, this skepticism persisted until Ernst Chain (pictured) and Edward Abraham published their own research into the subject in 1940.
Early Experiments: Testing the Mold’s Powers

Fleming conducted numerous experiments to test penicillin’s antibacterial properties. His findings were promising, showing that it could kill a wide range of bacteria without being toxic to human cells.
These early tests laid the groundwork for future research and development. Fleming’s meticulous documentation helped persuade others of penicillin’s potential, slowly turning the tide of skepticism.
The Struggle for Recognition: Penicillin’s Slow Start

Despite its promise, penicillin faced a slow start. Fleming struggled to gain widespread recognition and support for his discovery. Funding was scarce, and the challenge of mass-producing the antibiotic seemed insurmountable.
It took years before penicillin’s potential was fully realized, but Fleming’s perseverance eventually attracted the attention needed to push the discovery forward.
Howard Florey and Ernst Boris Chain: Reviving Fleming’s Work

The revival of Fleming’s work came through the efforts of Howard Florey (pictured) and Ernst Boris Chain. These scientists took on the challenge of purifying penicillin and demonstrating its effectiveness in treating infections.
Their work was instrumental in transforming penicillin from a laboratory curiosity into a life-saving drug. Florey and Chain’s contributions were crucial in overcoming the hurdles that had initially impeded its progress.
Mass Production Challenges: Getting Penicillin to the Public

One of the greatest challenges was producing penicillin on a large scale. The process was complex and costly, requiring innovative solutions to increase yield.
With the help of American pharmaceutical companies, new techniques were developed to mass-produce penicillin. The collaboration between scientists and industry was key to overcoming these obstacles, ensuring that penicillin could reach those in need.
The Impact of World War II: Accelerating Development

World War II played a significant role in accelerating penicillin’s development. The urgent need for effective treatments for wounded soldiers drove massive investment and research.
Penicillin became a top priority, leading to rapid advancements in production. By the end of the war, it was widely available, significantly reducing infection-related fatalities and solidifying its place as a medical marvel.
The First Clinical Trial: Saving Lives with Penicillin

The first clinical trials of penicillin were groundbreaking. Conducted in the early 1940s, these trials demonstrated penicillin’s ability to treat severe bacterial infections effectively.
Patients who would have otherwise faced dire consequences (Harry Lambert, for instance, had a life-threatening case of streptococcal meningitis) made remarkable recoveries. These successful trials were pivotal in proving penicillin’s worth, paving the way for its widespread use and changing the course of medical history.
The Nobel Prize: Recognition for a Game-Changing Discovery

In 1945, the Nobel Prize in Physiology or Medicine was awarded to Fleming, Florey, and Chain for their groundbreaking work on penicillin. This prestigious recognition was a testament to the monumental impact of their discovery.
The Nobel Prize brought global attention to penicillin, highlighting its role in advancing medicine and saving countless lives. It was a well-deserved accolade for a team whose work had fundamentally transformed healthcare.
Penicillin’s Legacy: Transforming Modern Medicine

Penicillin’s legacy is profound, having transformed modern medicine. It marked the beginning of the antibiotic era, providing doctors with a powerful tool to combat infections.
This discovery paved the way for the development of other antibiotics, significantly reducing mortality rates from bacterial diseases. Penicillin’s impact is still felt today, as it remains a vital part of medical treatment worldwide.
Beyond Penicillin: The Birth of Antibiotics

The success of penicillin spurred the search for other antibiotics. Researchers scoured the natural world for new compounds, leading to the discovery of medications like streptomycin and tetracycline.
This ushered in a new era of medicine, where bacterial infections could be effectively managed. The birth of antibiotics revolutionized healthcare, leading to improved outcomes for patients and a dramatic shift in the treatment of infectious diseases.
Lessons from History: The Role of Serendipity in Science

Penicillin’s discovery serves as a powerful reminder of the role of serendipity in science. Accidental discoveries can lead to significant advancements, highlighting the importance of curiosity and open-mindedness.
Scientists must remain vigilant and willing to explore unexpected findings. Penicillin’s story encourages a culture of exploration, where even the most unlikely observations can lead to groundbreaking innovations.
Modern Challenges: Antibiotic Resistance and the Future of Medicine
Despite its success, penicillin’s story continues with modern challenges such as antibiotic resistance. Overuse and misuse of antibiotics have led to the emergence of resistant bacteria, posing a significant threat to public health.
The medical community is now tasked with finding new solutions to combat these superbugs. Ongoing research and responsible antibiotic use are crucial to ensuring the continued effectiveness of treatments.

